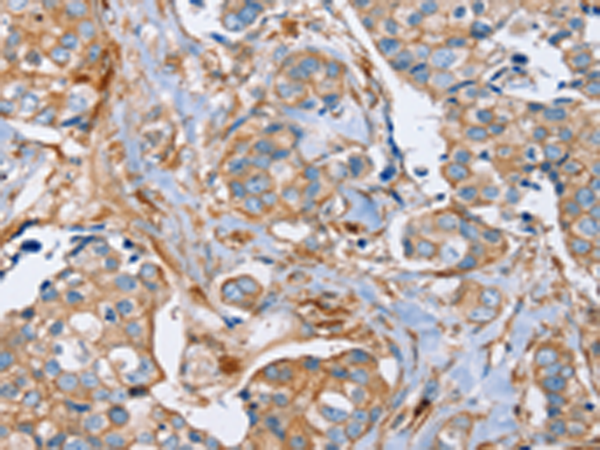
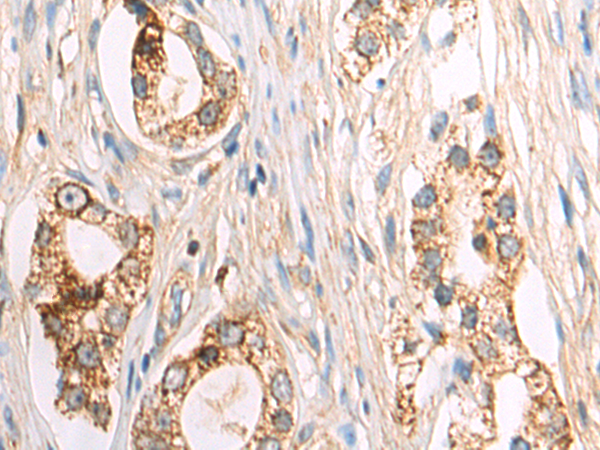

-
分类: 科研抗体货号: P08610别名: LMP1; LMP3应用: IHC反应种属: Human, Mouse, Rat
-
分类: 科研抗体货号: P08609别名: L9; ENH; LIM; ENH1应用: IHC反应种属: Human, Mouse, Rat
-
分类: 科研抗体货号: P08626别名: BMND18; T-plastin应用: WB,IHC反应种属: Human, Mouse, Rat
-
分类: 科研抗体货号: P08608别名: SLIM; MYSTIQUE应用: IHC反应种属: Human
-
分类: 科研抗体货号: P08644别名: P1; CT94.1应用: IHC反应种属: Human
-
分类: 科研抗体货号: P08623别名: DOD; UBL5应用: WB,IHC反应种属: Human, Mouse
-
分类: 科研抗体货号: P08607别名: CLIM1; CLP36; CLP-36; hCLIM1; HEL-S-112应用: WB反应种属: Human, Mouse, Rat
-
分类: 科研抗体货号: P08643别名: HH72; PRL1; PRL-1; PTPCAAX1; PTP(CAAX1)应用: IHC反应种属: Human, Mouse, Rat
-
分类: 科研抗体货号: P08622别名: FDFACT1; FDFACT2应用: IHC反应种属: Human
-
分类: 科研抗体货号: P08606别名: PDHBD; PHE1B; PDHE1B; PDHE1-B应用: WB,IHC反应种属: Human, Mouse, Rat

鄂公网安备42018502007531号
鄂公网安备42018502007531号

